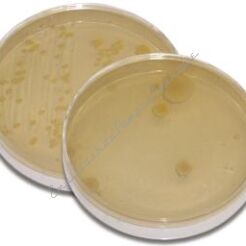
Jak czysta jest woda, którą pijemy i powietrze którym oddychamy? - zestaw klasowy

Jak czysta jest woda, którą pijemy i powietrze którym oddychamy? - zestaw klasowy
- Kod: 26566
-
- szt.
- Cena netto: 795,93 zł 979,00 zł
Za pomocą tego zestawu uczniowie pobierają próbki wody i powietrza, a następnie hodują przez noc mikroorganizmy. Bezpieczny i prosty sposób na naukę zanieczyszczeń.
- Dla 10 grup laboratoryjnych
- Hoduj przed noc, skończ w 30 min!
Dodatkowo wymagane: Mikroskop z powiększeniem 400x.
Informacja o dostawie: Zestaw zawiera instrukcję, szkiełka wielopunktowe (po 4 rodzaje komórek), bejcę z eozyną i błękitem metylenowym, pożywkę do zatapiania, szkiełka nakrywkowe, pipety transferowe oraz wanny zanurzeniowe.
Informacje o bezpieczeństwie produktu Informacje o producencie